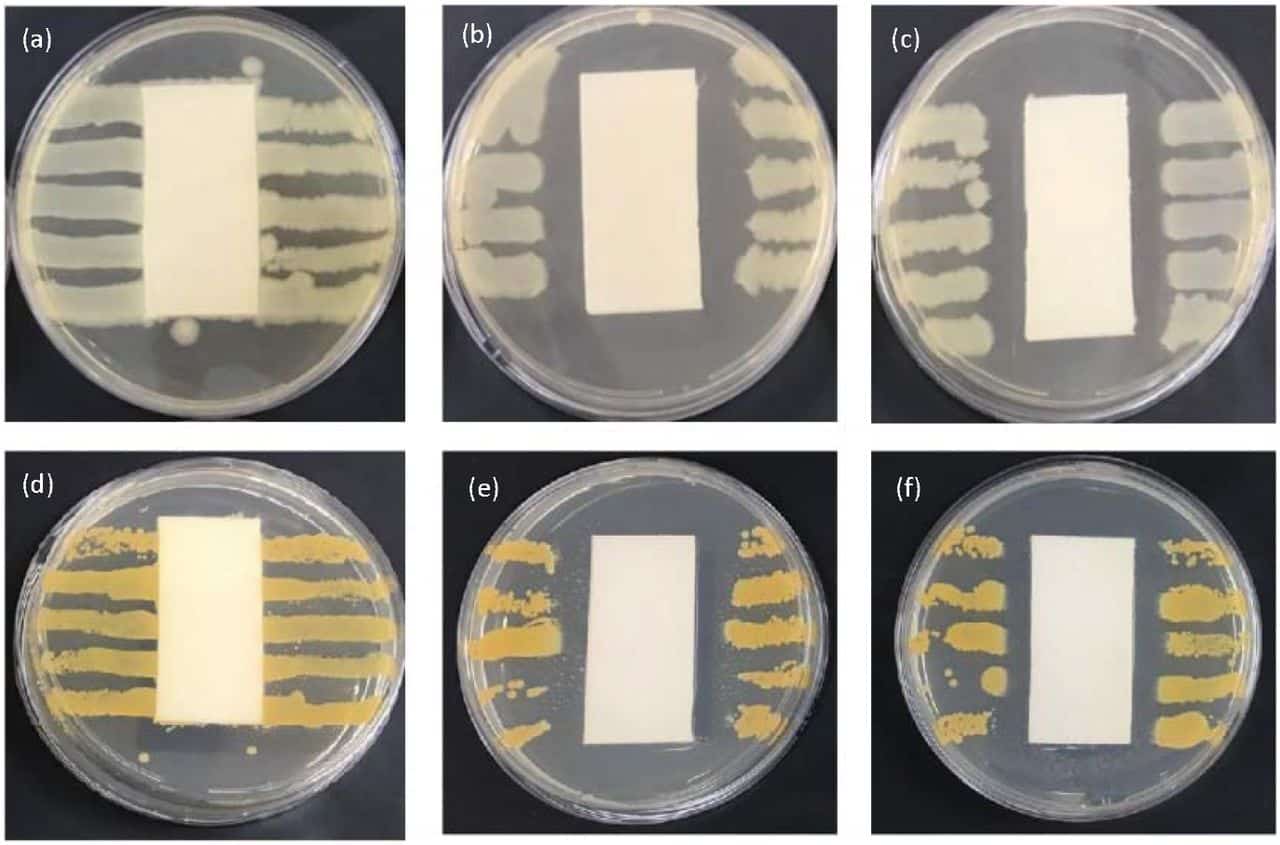

New Textiles With Antiviral Properties
Fabric companies from Brazil have actually begun manufacturing and marketing fabrics treated with silver and silica nanoparticles developed by the research teams at the Center for Functional Materials (CDMF) and the and Computational Chemistry Laboratory (QTC) at the Jaume I University, in collaboration with the firm Nanox Tecnologia, which provide the new textiles with antiviral, antifungal as well as antibacterial properties with the effectiveness of 99.99%.
The article titled “Ag nanoparticles-based antimicrobial polycotton fabrics to prevent the transmission and spread of coronavirus – SARS-CoV-2,” has been released as a preprint in the journal bioRxiv and is yet to be peer-reviewed. In the study, they demonstrate that using an aqueous solution of silver nanoparticles blended with an acrylic-based binder in poly-cotton fabrics works as an effective antimicrobial and also has high durability in regard to washing cycles.

Pathogens (viruses, bacteria, and fungus) are becoming a potential threat to human health and the environment globally. These pathogens widely exist in the environment, spreading quickly and easily causing infections and adverse reactions. Today, the humanity has experienced epidemic diseases caused by both new and well-known viruses, including coronavirus, HIV/AIDS, hepatitis C, MERS, Ebola virus, Zika virus, and Lassa fever, as well as Measles virus, Influenza, and Yellow Fever, despite the availability of vaccines they can be severe.
In this research, silver-based material is used to be incorporated and functionalized in polycotton fabrics using the pad-dry-cure technique. The study shows that the composite is effective for inhibiting the coronavirus by decreasing the number of replicates in 99.99% after 2 minutes of incubation.
Assessments have actually shown that the fabric is effective in inhibiting the coronavirus SARS-CoV-2, and 99.99% pathogens Candida albicans, Escherichia coil, as well as Staphylococcus aureus was inhibited. The other differential quality of these fabrics is the prevention of cross infections caused by pathogenic microorganisms, such as bacteria and opportunistic fungi, which worsens the COVID-19 and various other kinds of viral infections.
Most notably the fabric does not cause allergies referring to its safe use.
Author: Sruthi S

























